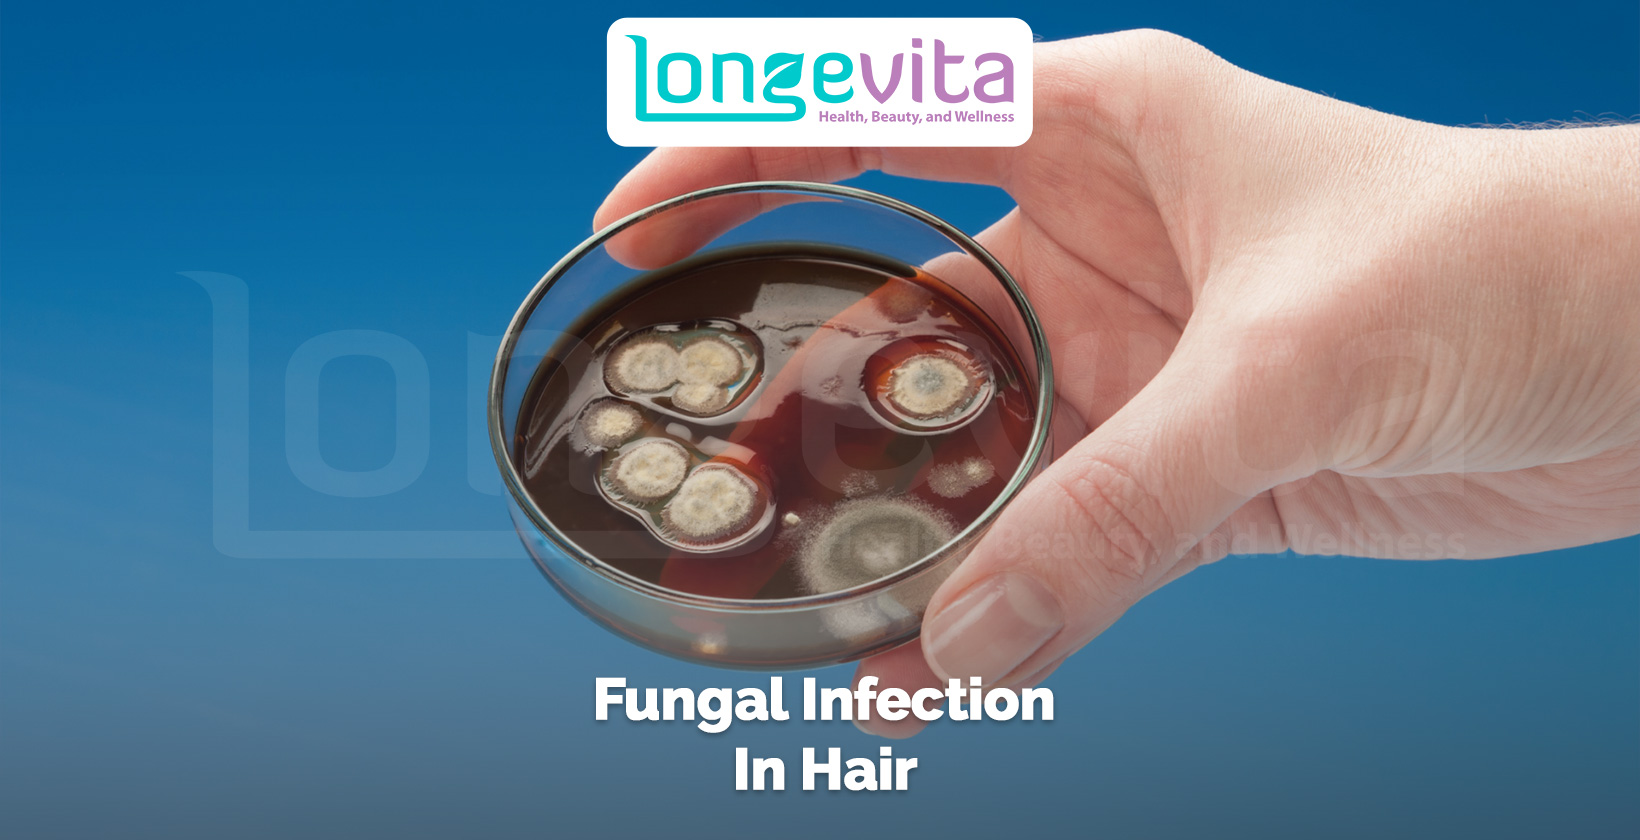
hand holding a petri dish with fungal colonies representing scalp infection

Fungi are one of those microorganisms, that no matter where you go, you can’t escape. It’s in the water, river, air, soil, plants, and animals, including human beings. They make a part of your gut microbiome, can be found in the mouth, and are even present on the surface of the skin.
They’re not always bad, though. In fact, some even help with immunity. However, they need to stay at optimal levels to not cause any harm. But there are different factors that can cause them to overgrow, leaving you with a fungal infection.
It can affect the most innocuous areas of the body, such as the hair on your scalp or the skin of the scalp itself. Unfortunately, you may end up experiencing hair loss because of it. It’s also important to note that you shouldn’t take fungal infection in the hair or scalp too lightly.
That’s because some of the more severe cases can also cause scarring and permanent hair loss from fungus. In this guide, you’ll learn more about the signs, causes, treatments, and risk factors of fungal infection of the hair.
What Is A Fungal Infection?
Diseases caused by fungi are known as fungal infections. According to a study published in Cold Spring Harbor Perspectives in Medicine, there are about 1.5 to 5 million species of fungus on this planet. However, only “several hundreds” of them can cause diseases in human beings.
A few of the more common fungal infections that you might be aware of are athlete’s foot, ringworm, thrush, or jock’s itch. Some of these infections are less severe, but there are others that can be far more serious and even fatal, such as mucormycosis, pneumocystis pneumonia or invasive candidiasis.
While it’s possible for anyone to get a fungal infection, according to the Centers for Disease Control and Prevention (CDC), these kinds of infections are “opportunistic.” They’ll try and get you when your immune system is down due to one reason or another (HIV, cancer, hospitalisation, medications weakening immune system, etc.).
While the common perception is that fungal infections are contagious. In fact, not all of them are. For instance, tinea versicolor is a type of non-contagious infection that can cause discoloration of the skin. Still, you must remain careful, and if you have any of its symptoms, make sure to get in touch with your doctor.
What Is Hair Fungus?
A hair fungus refers to a fungal infection on hair scalp or hair. It can even be inside the hair. Since there are more than a few, let’s take a closer look at each so you can get a better idea of them.
Dermatophytes
These are the most common fungal infections that affect the surface of the skin, causing “superficial skin infections.” One of the unique things about these is that they need keratin – a kind of protein found in the skin, nails, and hair – in order to grow. Therefore, as you can expect, these fungi can affect all these areas on the body.
As far as the scalp is concerned, you might know this fungus to cause tinea capitis or scalp ringworm. There’s no worm involved in this one. Only it’s so called because of the itchy, red, and “circular” patches that it can form on the scalp.

Keep in mind that this fungus can affect both the skin of the scalp and the hair itself (because keratin is found in both). Also, it doesn’t just affect the scalp, it can also infect the beard area, causing what’s known as tinea barbae.
But when it does infect, it can do so in three different ways, which are as follows:
- Endothrix – When the fungus invades the hair shaft and affects its interior. The breakage of the hair results in the appearance of black dots.
- Ectothrix – The fungus covers the exterior of the hair shaft and destroys the cuticle. It can cause scaliness, inflammation and hair loss.
- Favus – It’s a very serious form of tinea capitis, also known as tinea favosa. In this, crusts can form which group together to form a honeycomb pattern (favus means honeycomb). It can also cause hair loss.
Furthermore, it should be noted that there are two types of tinea capitis: inflammatory and non-inflammatory. In the non-inflammatory one, you’re likely to see black dots on the scalp. But it can also be a grey patch tinea capitis. In both of them, you don’t have to worry about permanent fungal infection hair loss.
In the inflammatory type, on the other hand, things are much complicated by the formation of a longstanding kerion – an abscess. It can cause scarring (unfortunately, you might not be suitable for a hair transplant in Turkey or elsewhere in such a scenario – still, consult a doctor).
And it can leave you with permanent bald spots. There are other inflammatory types as well, such as Majocchi granuloma and mycetoma.
Piedra
Piedra is another type of fungal infection that affects the hair shaft. “Piedra” itself means a stone or rock, and this infection is referred to as such because it forms stony nodules on the hair. There are two types of this infection, which are as follows:
- White Piedra – It’s a rare fungal infection that forms white or beige nodules on the tip of the hair shaft. More commonly, it affects facial and body hair (groin and armpits), but it can also occur on the scalp.

- Black Piedra – In black piedra, as you have guessed, the nodules are darker coloured. However, in contrast to white piedra, they are also harder and more strongly attached to the shaft. Additionally, they also make the hair more fragile.
Yeasts
Yeast is the kind of fungus that’s found on the skin, in the digestive system, and even the vagina. However, again, the overgrowth of this fungus can also end up causing an infection.
When it comes to the scalp, however, there are two types of yeasts that can cause an infection: Candida and Malassezia.
Unfortunately, both of these can end up causing fungal hair loss. In Candida, the skin of your scalp can be affected, and you might end up with an itchy and flaky rash on your scalp.
In Malassezia, the fungus in hair follicles can cause inflammation. It’s known as Malassezia folliculitis and forms itchy acne on the skin.
It should also be noted that the Malassezia yeast has also been linked to a type of skin condition known as seborrheic dermatitis. And that can also cause hair loss indirectly.

What Are The Symptoms Of Fungal Infection In The Hair?
The symptoms of the fungal infection of the hair can vary depending on the kind of infection you have.
If you have tinea capitis or ringworm, you may experience the following:
- Bald circular patches on the scalp (may have black dots)
- Itchiness and pain
- Redness and swelling
- Scaliness
- Dryness and flakiness (might look like dandruff)
- Oozing blisters (kerion)
Piedra, on the other hand, may occur without any symptoms. According to Medscape, however, you may feel the gritty nodules on your hair even if you’re not able to see them.
Also, strangely, you might hear a “metallic sound” on brushing hair with piedra. White piedra can also cause pain and itchiness (the latter usually doesn’t happen in black piedra).
If you have a scalp yeast infection, in that case, you might have the following symptoms:
- Itchiness and red patches
- White, flaky scales
- Crusting (that can lead to hair loss)
- Pus-filled pimples
- Greasy scales
Again, keep in mind that symptoms can vary, so make sure to get in touch with a medical professional.
Do Fungal Infections Cause Hair Loss?
Fungal infections can cause hair loss by directly affecting the hair shaft or the surrounding skin.
Tinea capitis can cause both temporary and permanent hair loss. The latter happens in the case of a kerion formation.

According to the Mayo Clinic, when you have a kerion, you can easily pull the hair out. And because it can cause scarring, it can lead to permanent hair loss.
In piedra too, you can experience hair loss because of the fragility of the hair shaft. That can make it break easily, which may cause thinning.
Lastly, yeast infections of the scalp can also damage the hair follicles on your scalp and cause hair loss.
What Are Hair Fungus’ Causes?
Different types of fungi can affect your hair due to different factors. As far as tinea capitis is concerned, the problem with it is that it’s quite contagious.
And you can develop it by coming in contact with an infected person, animal or object (e.g. combs and clothes). Tinea capitis is also more common in children below the age of 12.
Moreover, it should be noted that this fungus likes hot and humid environments. And according to StatPearls, it is found more commonly in Africa, Southeast Asia and Central America. Therefore, there can be regional differences as well.
When it comes to piedra, Medscape reports that it could be due to the environment or the skin flora. Still, it’s not exactly understood how this infection is transmitted to human beings. It’s also more common in the hot and tropical regions of the world.
Yeast infections are also caused by the overgrowth of these organisms on the body. But there can also be other factors at play. For instance, Candida likes heat and humidity. Moreover, some chemicals in grooming products may also allow it to thrive.
How To Treat Fungus In Hair?
The treatment for a fungal infection in hair may include:
- Topical ointments
- Shampoos
- Oral medication
Hair fungus treatment can depend on the type of infection you have and its severity. For scalp ringworm, you may have to take oral antifungals for a month and a half.
Usually, it’s griseofulvin that’s prescribed. Additionally, you might be prescribed a ketoconazole, selenium sulfide or salicylic acid containing shampoo to not let the infection spread. But keep in mind that it’s given alongside oral medication.
Other than that, according to the CDC, “creams, lotions or powders” do not work for tinea capitis of the scalp. So, make sure to follow the instructions of your doctor, and your hair should start to regrow.
For piedra, you’ll have to shave off all the infected hair on your scalp as it gets rid of the infection. Other than that, you might be given topical shampoos (ketoconazole, miconazole, selenium sulfide, etc.), creams or lotions, especially if you’re not willing to shave your hair off.
If the topical treatment isn’t working out for you, you might be prescribed oral medications, such as terbinafine or itraconazole.
Scalp yeast infections are also treated with shampoos, foams, or ointments. And when it comes to these fungal infections, some people also experiment with home remedies that use apple cider vinegar, coconut oil, tea tree oil or other essential oils.
The problem with the latter is that they aren’t well-researched, and before you consider using them, you must consult your doctor about them as a treatment for fungal infection for the hair.
Who Gets Hair Fungus?
Certain factors might make you more vulnerable to getting fungus in your hair. As mentioned above, fungal infections do tend to be opportunistic.
For tinea capitis, risk factors can include:
- Young age and school-going children
- Living in a place that’s full of moisture and hot
- Living in the vicinity of objects, animals or persons that are infected
- Playing contact sports
Piedra, as mentioned above, is more common in hot and tropical regions so you might be at a greater risk of developing it if you live in such regions. Poor hygiene may also cause this condition.
Lastly, for scalp yeast infections, you might be more likely to develop it if you have:
- HIV/AIDS
- Weak immune system
- Cancer
- Diabetes
- Thyroid disease
- Stem cell transplant
Other than that, antibiotics can also increase the risk of yeast infections. And steroids can do the same or even worsen an existing infection.
How To Prevent Fungal Infection Of The Hair?
In general, you might be able to prevent a fungal hair infection by:
- Avoid sharing your combs, towels, clothing, and other objects with other people.
- Try to keep your scalp clean and dry.
- Don’t keep your scalp covered for long periods if possible (especially if you live in a hot and humid place).
- Eat well and maintain good hygiene.
- Wash your hands after touching an animal.
Also, if you’ve already developed an infection, make sure to follow your treatment plan to avoid the spread of this infection.
Conclusion
Hair fungus might seem like a nuisance, but it is something that you shouldn’t take so lightly. While some people try to treat them at home by trying some oils or other kitchen staples, you might get in touch with a doctor.
Also, keep in mind that these infections tend to occur more commonly in some places and certain circumstances. So, you need to be extra careful there. Fortunately, there are treatments available for different hair fungal infections.
But you must not delay treatment as your infection might worsen and even lead to permanent loss of hair. You will, however, need to go to a doctor first for an accurate diagnosis and treatment plan.
Dr Cagla
Dr Cagla earned her medical degree at Trakya University’s Faculty of Medicine in Bulgaria and has almost 6 years of hair transplantation experience. She is a specialist in FUE, DHI and Sapphire hair transplants of the scalp, eyebrows and beard and has performed over 6,000 surgeries. Dr Cagla is multilingual, with fluency in English, Bulgarian and Turkish.